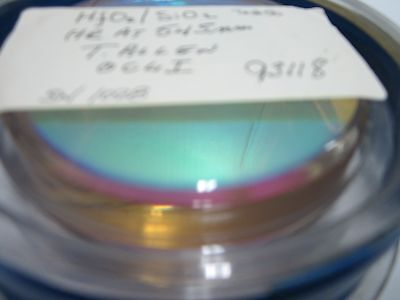
OPTISCHES HAFNIUMOXID DICHROIC FLACHSPIEGEL ZERODUR LASEROPTIK BIN#R1-30

OPTISCHES HAFNIUMOXID DICHROIC FLACHSPIEGEL ZERODUR LASEROPTIK BIN#R1-30
OPTISCHES HAFNIUMOXID DICHROIC FLACHSPIEGEL ZERODUR LASEROPTIK BIN#R1-30
Schott AG
Verfügbarkeit für Abholungen konnte nicht geladen werden
Artikelbeschreibung:
OPTICAL HAFNIUM OXIDE DICHROIC FLAT MIRROR ZERODUR LASER OPTICS BIN#R1-30
Sold as is. Thanks.
TERMS OF USE
Welcome to our SILO Ebay store. Please, review our terms and conditions, which has the purpose to clarify and help for a better business relationship with our customers. If you do not agree with any part of our company policies, please do not do any bidding in our items. IF YOU PLACE A BID IN OUR ITEMS We’ll consider that you have agreed to all the following Term of Use.
ITEM CONDITIONS: Please, make a thoroughly inspection of the photos, description and conditions of each item you are interested, before placing your biding. SILO attempts to be as accurate as possible. However, SILO does not warrant that product descriptions or other content is accurate, complete, reliable, current, or error-free. If a product offered in our store is not as described, your sole remedy is to return it in unused condition.
DISCLAIMER: Many of our items are previously USED products or REFURSBISHED, therefore they are sold “with all faults” or “AS IS”, unless otherwise specify in writing. The condition of the item is provided in the “description”.
RETURN POLICY: Our goal is to provide our customer with the best option for their needs. If you need to return item this rules will apply:
We offer the buyer a two weeks (14 days) right to return the item. The buyer will be responsible for the cost of packing and shipping the item.
Items MUST BE returned for any Refund. We do not offer partial refunds. Refunds will be given as money back.
WARRANTIES OR RETURNS: NO WARRANTIES ARE EXPRESS OR IMPLIED. Items that are supposed to be operational according to the description in the listing can be returned if they are D.O.D. Items that are untested or are sold ‘AS IS’ can not be returned.
DISCLAIMER OF WARRANTIES AND LIMITATION OF LIABILITY: All ITEMS OR PRODUCTS LISTED IN OUR EBAY STORE ARE PROVIDED BY SILO ON AN "AS IS" AND "AS AVAILABLE" BASIS, UNLESS OTHERWISE SPECIFIED IN WRITING. OUR SILO STORE MAKES NO REPRESENTATIONS OR WARRANTIES OF ANY KIND, EXPRESS OR IMPLIED, AS TO THE OPERATION OF ANY OF THE ITEMS LISTED, UNLESS OTHERWISE SPECIFIED IN WRITING. YOU EXPRESSLY AGREE THAT YOUR PURCHASE IS AT YOUR SOLE RISK. TO THE FULL EXTENT PERMISSIBLE BY APPLICABLE LAW, SILO STORE DISCLAIMS ALL WARRANTIES, EXPRESS OR IMPLIED, INCLUDING, BUT NOT LIMITED TO, IMPLIED WARRANTIES OF MERCHANTABILITY AND FITNESS FOR A PARTICULAR PURPOSE. SILO WILL NOT BE LIABLE FOR ANY DAMAGES OF ANY KIND ARISING FROM THE USE OF ANY PRODUCTS PURCHASED THROUGH OUR EBAY STORE, INCLUDING, BUT NOT LIMITED TO DIRECT, INDIRECT, INCIDENTAL, PUNITIVE, AND CONSEQUENTIAL DAMAGES, UNLESS OTHERWISE SPECIFIED IN WRITING.
PAYMENT AND TAXES: Payment must be received within 7 days of the purchase date.
We only accept payment through PAYPAL.
For International orders we also accept PayPal and Bank Wire Transfer, but we reserve the right to refuse some kind of payment at our discretion. Decisions will be taken in case by case scenario due to previous problem with some international bank institutions.
California residents will be charge with 9% Sales Tax.
IMPORTANT INFORMATION FOR INTERNATIONAL BUYERS
WE DO NOT make false statements on Custom Documentations. A purchased item will not be sent “as gift” and the value declared will be the price paid at the purchase.
PLEASE, we aware that your purchase might be subject to custom duties, import restrictions and value-added taxes. IT IS YOUR RESPONSIBILITY to know all legal requirements for your purchase BEFORE you place a bidding.
As a consequence of the widely different level of functioning of postal service around the word, we cannot guarantee delivery outside of the USA. For this reason, we highly recommend and many times required “certificate delivery” and insurance.
If the item is returned or rejected from your country for any reason, we will refund you the cost of the items less any eBay fees and shipping cost.
By placing a bid and eventually buying the item, YOU ARE CONFIRMING THAT YOU HAVE READ AND AGREED to this term of use, specifically regarding to the international sales, and these requirements are incorporated into the eBay sales terms.
SALES LIMITATION: Some of the items listed on our store are only available within USA. Please make sure the item you selected could be sent to the country of destination you decided before engaging in any purchase.
SHIPPING: We usually ship within 3 days of receiving cleared payment. We only combine items purchased and paid within the same calendar week (Monday through Friday).
NO LOCAL PICK UP allowed.
JURISDICTION: The Court in Los Angeles County, California will have exclusive jurisdiction in all dispute relate to the purchase of items through our eBay Store.
CHOICE OF LAW: These terms and conditions will be governed and construed in accordance with California law.
Menge auf Lager:
Niedriger Lagerbestand: 1 verbleibend
Erklärung zu Einkäufen
Erklärung zu Einkäufen
SILO Surplus versucht, so genau wie möglich zu sein. Wir können jedoch nicht garantieren, dass Produktbeschreibungen oder andere Inhalte vollständig genau, vollständig, zuverlässig, aktuell oder fehlerfrei sind. Dementsprechend werden alle Artikel in ihrem Ist-Zustand verkauft. Bitte überprüfen Sie vor dem Kauf die Fotos, Beschreibungen und Bedingungen jedes Artikels, an dem Sie interessiert sind, gründlich. Wenn ein in unserem Geschäft angebotenes Produkt nicht der Beschreibung entspricht, kontaktieren Sie uns bitte umgehend, damit wir eine Rücksendung veranlassen oder die Situation anderweitig bereinigen können.
Angebote und Rabatte
Angebote und Rabatte
Wir sind offen für Angebote für Artikel unter dem Listenpreis oder für Rabatte auf Preis oder Versandkosten. Um Produktangebote anzufragen, senden Sie uns bitte eine E-Mail oder verwenden Sie das unten stehende Kontaktformular und geben Sie die entsprechenden Produkttitel an, wie sie auf unserer Website erscheinen.






Wenn Sie Fragen haben, lassen Sie es uns wissen!
Wenn Sie Fragen zu diesem bestimmten Produkt haben, schreiben Sie uns bitte eine E-Mail mit dem Produkttitel und wir werden uns mit allen möglichen weiteren Informationen bei Ihnen melden.